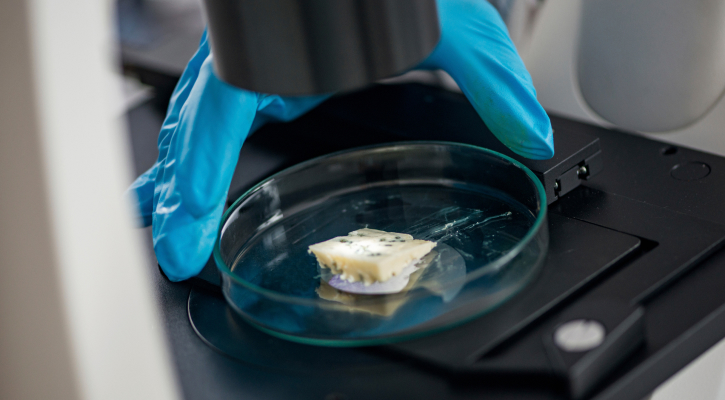

고객분들께 최고의 느타리버섯을 제공하기 위해서는 제조부터 생산까지
전 과정에 걸쳐 철저한 연구가 필요하다고 생각했습니다.
그래서 저희는 23년간의 엄격한 연구를 통해 칼디여왕(아이작버섯농장)만의 독자적인 품질을
구현하였으며, 그 결과 건강하고 우수한 느타리버섯을 탄생시킬 수 있었습니다.
신선하고 건강한 먹거리를 제공하는 것이 칼디여왕의 소중한 목표입니다.

원료부터 배합기술 모든 노하우는 22년간의 연구개발을 통해 축적 되었으며, 자연친화적 환경제어, 관리제어로 버섯 종균을 건강하게 만들어 버섯 생산하는 기술을 보유하고 있습니다.

자체 시험결과 칼디여왕(아이작버섯농장)의 건조 느타리버섯은 비타민D2 (1800㎍/100g) 일반 건조 느타리버섯 비타민 D2(16㎍/100g)보다
월등히 높으며, 연구 개발을 통해 더욱 건강한 버섯 생산에 최선을 다하고 있습니다.
*상기 시험 자료는 자체 연구자료이므로 참고만 하세요.

버섯 종균 연구개발부터 배지 생산, 생육실을 거쳐 버섯 생산까지 원스톱으로 관리하는 아이작 느타리 버섯.
버섯의 성장과 관리를 위해 필수적으로 생태환경제어를 하기 때문에 약품처리를 할 경우 버섯 발달 장애로 생산이 불가능합니다.
매우 조심스럽게 안전하게 관리하는 아이작 느타리버섯으로 안전 먹거리를 책임집니다.